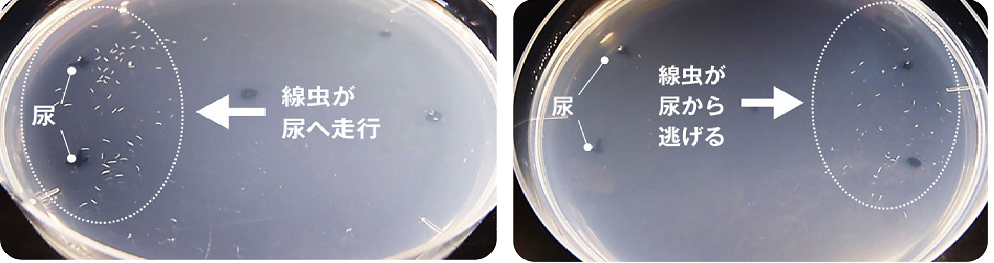

九大発ベンチャーの線虫がん検査は初期すい臓がん発見に有用 阪大など研究グループ
大阪大学最先端医療イノベーションセンターの石井秀始特任教授らの研究グループが、九州大学発ベンチャーの線虫がん検査「N-NOSE(エヌ・ノーズ)」の技術は初期膵(すい)臓がんの発見に有用とする研究結果を公表した。
膵臓がんは診断と治療が難しい。診断できた段階で手術可能な患者は約20%。切除できても術後の再発率が高い。術後5年経過後に生存する患者の比率「5年生存率」は20%~40%。日本人の部位別がん死亡者数は4番目に多い。
その一方で膵臓細胞の突然変異からがん発症までは21年ほどかかるとされ、早期発見できる技術開発が求められている。現在は、血液検査でわかるCEA(がん胎児性抗原)やCA19-9といった腫瘍マーカーとCТ、超音波などの画像診断を組み合わせる検査方法が一般的。
「N-NOSE」は、“匂い”を感知する能力が高い線虫の嗅覚に着目した検査方法。ヒトの尿を採取して、シャーレ上の寒天プレートの中央に線虫、片側に尿を置き、線虫がどちら側に動くかによって、がん罹(り)患の可能性を調べる。
線虫は体長約1mm。がん罹患者の尿の匂いを好んで集まる半面、健康人の尿の匂いを嫌がって離れていく。
研究グループは、2015年10月~19年6月まで登録した膵臓がん患者83人(ステージ0-Ⅳ)の手術前と手術後の尿を採取、線虫の走性行動を解析した。
その結果、手術前の尿に線虫は近づき、手術後の尿からは離れた。
さらに患者83人のうちステージ0-1Aの初期患者11人と健康人17人の尿を使用した走性行動の解析でも、線虫は初期患者の尿に近づくものの、健康人の尿からは離れることを識別できた。
これに対し初期患者のCEAとCA19-9の感度(陽性を陽性と正しく判定する確率)は、線虫の走性行動(線虫の嗅覚)の感度を下回った。
この研究結果は米国科学誌『Oncotarget(腫瘍学)』オンライン版8月号に掲載された。このなかで研究グループは(1)登録患者数が不十分、(2)膵臓がん患者の尿の匂いが、がん性病変か膵臓機能障害による代謝障がいのどちらに由来するか不明、(3)初期膵臓がん患者に対する検出システムの病態識別値が決まっておらず、同システムをスクリーニング検査に使うためには高い特異度(陰性を正しく陰性と判定する確率)が不可欠と問題点も指摘している。
がん患者の尿と健康人の尿を線虫が嗅ぎ分けることは15年、九州大学大学院理学研究院助教だった広津崇亮氏が海外の科学雑誌に投稿し広く知られるようになった。
広津氏は翌16年8月、「(株)HIROYSUOバイオサイエンス」を設立し線虫によるがん検査キットをがんの1次検診用に発売。同社によると、19年9月現在、肺がんや胃がんなど15種類のがん種が線虫の反応でわかるが、がん種の区別はできない。
【南里秀之】